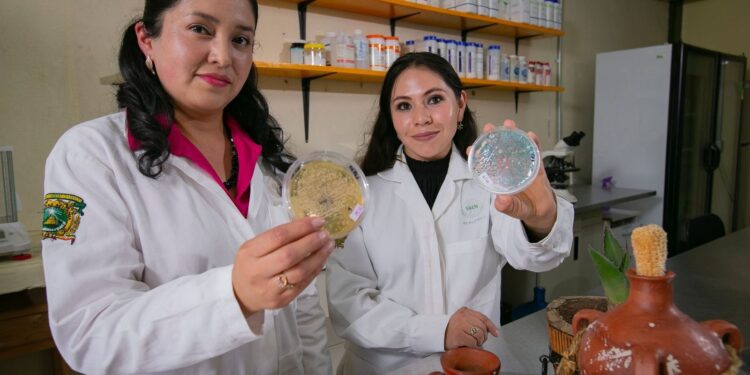
Rosa Laura Ocaña de Jesús comenzó una investigación sobre el proceso real de fermentación en el municipio de Jiquipilco.

Con el fin de desmentir los mitos existentes sobre la elaboración y fermentación del pulque, Rosa Laura Ocaña de Jesús, investigadora de la Facultad de Ciencias Agrícolas de la Universidad Autónoma del Estado de México (UAEMéx), analiza microbiológicamente esta bebida prehispánica producida en el municipio mexiquense de Jiquipilco.
El pulque se obtiene de una fermentación alcohólica natural que ha formado parte de la cultura mexicana, ancestralmente, era considerada como “la bebida de los dioses”.
Este líquido se extrae de la planta de maguey con un periodo previo de maduración de 7 a 15 años. Se perfora una cavidad en su corazón, raspándola para obtener su savia dulce llamada “aguamiel”. Este proceso es realizado por el tlachiquero quien con ayuda de un recipiente alargado y hueco llamado “acocote” succiona el aguamiel y lo vierte en un barril o cuero de borrego o cabra para transportarlo.
El aguamiel se traslada a un espacio limpio y preferentemente cerrado conocido como tinacal, donde se encuentran las tinas de fermentación, tinas de plástico (anteriormente de madera), que son fáciles de lavar y donde comienza el proceso de fermentación, de la cual se pueden obtener tres tipos de pulque: la semilla, un fermentado intermedio y un fermentado fuerte o mayormente concentrado, dependiendo del tiempo de fermentación que se desee obtener.
A pesar de que el pulque es una bebida única por su proceso de producción tradicional, donde en la época prehispánica y durante el porfiriato tuvo un gran auge, se vio afectado por su carácter perecedero y mitos generados por la industria cervecera para desplazarlo del mercado. Entre los mitos más famosos está el uso de una “muñeca”, es decir, excremento envuelto en una tela para la fermentación de la bebida, así como el uso de líquidos como la orina para el mismo proceso, estas creencias han desprestigiado la bebida y su consumo ha disminuido.
Rosa Ocaña entendió esta problemática y comenzó una investigación sobre las propiedades del pulque y su proceso real de fermentación. Su trabajo se realizó en Jiquipilco, Estado de México, un municipio que produce aproximadamente el 45 por ciento del pulque consumido a nivel estatal, además de ser una zona que celebra la “Feria del Pulque” en el mes de marzo.
La investigadora aseguró que el pulque cuenta con un gran aporte benéfico a la salud de los consumidores, pues es una fuente rica en nutrientes como proteínas, vitaminas y minerales. En este análisis se hallaron bacterias ácido-lácticas, donde se encuentran probióticos y levaduras, responsables de la fermentación del producto, y negó la existencia de microorganismos de origen fecal en pulque hecho por productores de Jiquipilco.
Pero la responsabilidad del productor es importante para garantizar que el pulque es auténtico y que cumple con todas las medidas de calidad e inocuidad para su consumo, se aconseja comprar este producto directamente con los productores: “Pudimos notar una diferencia entre personas que dicen ser productoras, pero realmente son revendedores y la calidad entre ellos es muy marcada porque en los revendedores sí encontramos microorganismos de origen fecal” resaltó Ocaña de Jesús.
Con esta investigación, se pretende identificar las prácticas que llevan a cabo los productores de pulque para mejorarlas y asegurar que el producto sea de buena calidad y no alterar la inocuidad ni las propiedades benéficas que posee, para que el pulque sea consumido y que no se vea afectado.

Rosa Ocaña invitó a las mujeres y niñas a involucrarse en la ciencia, pues la investigación y el conocimiento son fundamentales para eliminar las brechas existentes entre hombres y mujeres, donde el sexo femenino tiene que seguir tomando fuerza y necesita apoyo de todas las futuras científicas e investigadoras.